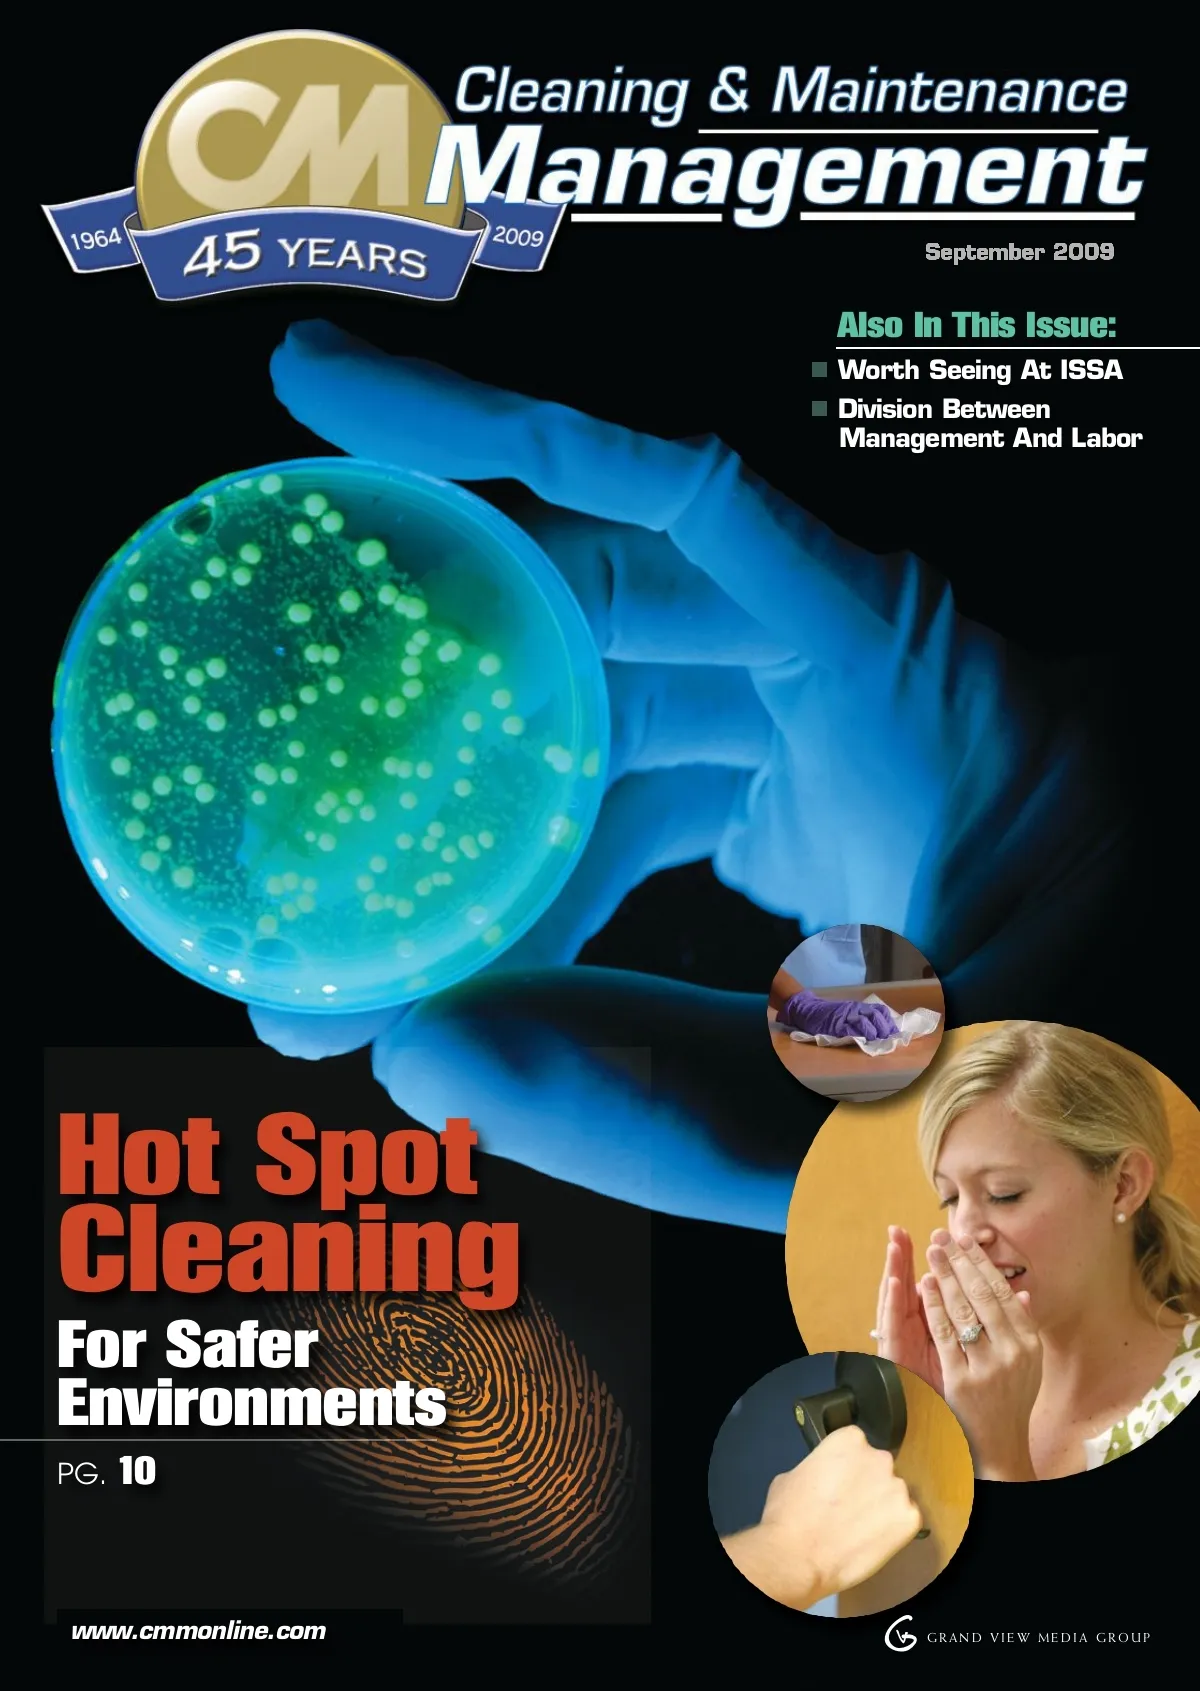

Also In This Issue: Worth Seeing At ISSA Division Between Management And Labor Hot Spot For Safer Environments PG. 10 Cleaning www.cmmonline.com V G GRAND VIEW MEDIA GROUP
CMM – Archives Sept 2009: Cover


Also In This Issue: Worth Seeing At ISSA Division Between Management And Labor Hot Spot For Safer Environments PG. 10 Cleaning www.cmmonline.com V G GRAND VIEW MEDIA GROUP